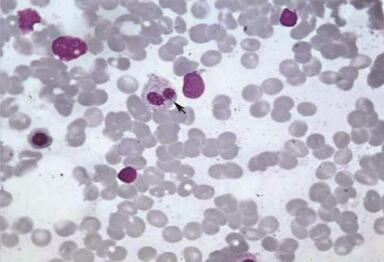

大叔全身乏力、骨痛伴下肢水肿 血常规发现血细胞减低
56岁男性,因全身乏力,全身骨痛酸痛不适,双下肢轻度水肿,查血常规发现血细胞减低入院。完善相关检查后,发现该患者原来患有……
【简要病史】
患者,男,56岁,因全身乏力,全身骨痛酸痛不适,双下肢轻度水肿,查血常规发现血细胞减低入院。入院检查:体温、血压、脉搏正常;查体:神清,精神软,贫血貌。
【相关检查】
血常规:WBC 1.4×109/L,L 50%,RBC 3.48×1012/L,Hb 128g/L,MCV 103.2 fl,MCH 36.7pg,PLT 70×109/L。骨髓检查:骨髓增生低下,巨核细胞减少,原始细胞占8%,伴多系病态造血现象,考虑MDS-RAEBI。骨髓流式细胞学检查:表达CD34(41.87),CD13(26.61),CD71(25.47),CD117(36.82),MPO(42.51),HLA-DR(95.69),而CD56、CD65s、CD14、CD15、CD16、CD64等阴性,结论:可符合MDS改变。予安特尔、反应停及维A酸等治疗,此后多次复查骨髓形态学:原始细胞在6.5%~11%范围。流式细胞学检查:2011年4月:表达CD33、CD64、CD56、CD2、CD71、HLA-DR及CD117小部分阳性,CD13极弱阳性,而CD7、CD19、CD34、CD14、CD15、CD16、CD10等阴性,结论:原始髓系细胞群约占非红细胞系细胞的19.19%;2011年11月:CD56+(双峰表达),CD117+(双峰表达),HLA-DR+++,CD2+(双峰表达),而CD33、CD7、CD10、CD11b、CD13、CD14、CD15、CD19、CD64、CD65s等阴性,结论:原始髓系细胞群约占非红细胞系细胞的15.22%。2012年3月患者背部、腰部、腹部出现皮疹,无瘙痒。复查血常规:WBC 0.9×109/L,N 44.5%,L 50%,RBC 3.48×1012/L,Hb 89g/L,PLT 53×109/L。2012年5月复查骨髓:增生低下,一类原始淋巴样细胞占94.5%,此类细胞胞浆中可见空泡、伪足样突出、嗜天青颗粒及包涵体,部分细胞核不规则。组织化学染色POX-,SB-,NSE-,NAF不显色。
【典型图片】
骨髓片

图1 原始细胞,×1000

图2 双小圆核巨核细胞
图3 中性粒细胞类P-H畸形,×1000

图4 原始幼稚样淋巴细胞,×1000

图5 包涵体,×1000

图6 皮肤外观明显皮疹
【讨论】
甲:MDS急变成AML-M0?
乙:患者皮疹,结合细胞形态和流式细胞分析结果,考虑NK细胞淋巴瘤。
丙:该病例自2011年一直追踪到2012年,做了多次流式细胞免疫分析,细胞表型的演变已突破MDS通常转化为急性髓系白血病的认识,虽然MDS中原始细胞CD56较常见,但该例髓系抗原完全消失,仅表达NK抗原,少见,考虑可能是髓系/NK祖细胞白血病,髄系抗原的消失,或者合并NK和急性淋巴细胞白血病。
丁:双峰表达不代表两类细胞,而说明这类细胞在抗原表达上存在一定异质性。
【分析】
流式细胞学检查结果:CD56、HLA-DR、CD2高表达,CD71极弱阳性,CD34及其他髓系标记及淋系细胞标记CD33、CD13、CD117、CD14、CD15、MPO、CD3、CD5、CD7、CD10、CD19、CD25、CD61、CD64、CD65s、CyCD79a、CIgM均阴性,考虑原始NK细胞白血病。骨髓病理活检:镜检示造血细胞增生活跃,细胞较单一、幼稚细胞染色无异常,免疫组化检查:CD3,CD20,CD138-,CD45(LCA)+,MPO-,病理结论:幼稚细胞增生,考虑MDS急淋转化。最终诊断:原始NK细胞白血病。
据MIC协作组的资料,大约21%的MDS最终会转化为急性白血病,MDS转化的急性白血病类型主要是AML,以AML-M2、AML-M4和AML-M5为主。据Sato N等统计,至今为止,MDS转化为ALL的报道仅有三十几例,而MDS转化为原始NK细胞白血病更是极为罕见。NK细胞被认为是非T非B第三类淋巴细胞,原始NK细胞白血病有其独特的免疫表型:HLA-DR+,CD56+,CD4+,可有或无CD71表达,无其他髓系和T、B系抗原,免疫分型为诊断的主要依据;
形态学特点:形态似原始淋巴细胞,细胞核可不规则,核仁明显,胞浆中空泡和伪足样突出是其特点,部分有嗜苯胺蓝颗粒;细胞化学染色POX、SB、NSE、NaF-;大约64%的原始NK细胞白血病以皮损为首发表现;少数原始NK细胞有TCR重排。该患者后期转化为急性NK细胞白血病,免疫表型CD56+,HLA-DR+,CD2+,CyCD3-,其他髓系和B系、T系抗原均阴性,同时骨髓形态学、细胞化学染色等均符合原始NK细胞特点。患者有明显皮损这也符合NK细胞白血病的侵袭性特点,我们由此推断该MDS患者转化为原始NK细胞白血病。入院后予VDCP化疗,骨髓缓解。
皮肤母细胞性NK细胞淋巴瘤实际是来源于一种具有髓系单核系/NK系双表型特征的早期干细胞,也被称为浆细胞样树突细胞(plasmacytoid dentritic cell neoplasm,PDC,又称DC2),DC2这种细胞具有独特的生物学行为,可同时表达T系标记CD4,NK系标记CD56,单核系标记CD36、CD68,在合适的刺激下可分化为各种成熟的功能细胞(包括单核细胞、NK细胞等)。因此这例MDS患者可能原有单核系恶性克隆存在,而慢慢转化为原始NK细胞白血病。
【诊断】
MDS转化为原始NK细胞白血病。
作者:李建虎 审核:李宏波
(环球医学编辑:余霞霞)
来源:《特殊血液病分析100例》
作者:吴茅 王福斌 林慧君 冯晓
页码:83-85
出版:人民卫生出版社
- 评价此内容
- 我要打分
近期推荐
热门关键词
合作伙伴
Copyright g-medon.com All Rights Reserved 环球医学资讯 未经授权请勿转载!
网络实名:环球医学:京ICP备08004413号-2
关于我们|
我们的服务|版权及责任声明|联系我们
互联网药品信息服务资格证书(京)-经营性-2017-0027
互联网医疗保健信息服务复核同意书 京卫计网审[2015]第0344号




会员登录

